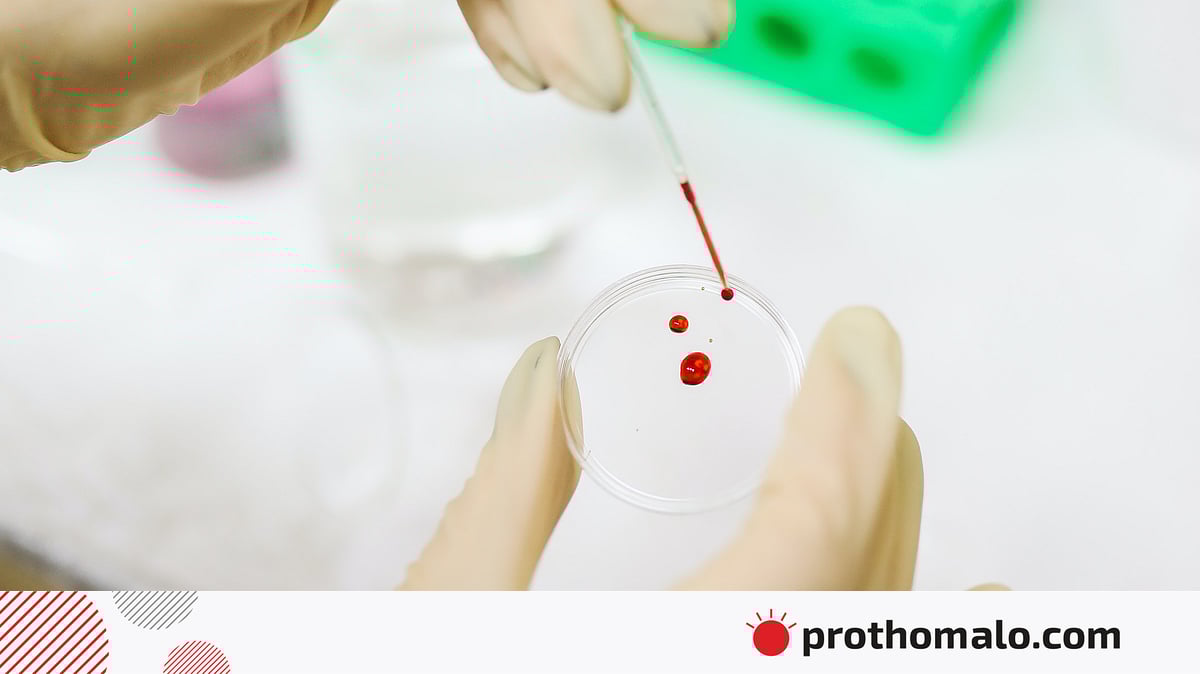
Lili Lamour porno Ayollar mushukchalariga katta narsalarni qoyishadi

Politsiya transgender fohishalarni hibsga oldi
Ruhiy muvozanat, erkinlik, madaniy va va emotsional qoniqish manbaiga aylanishi tarbiya haqida keng malumot bermoqda.













Ruhiy muvozanat, erkinlik, madaniy va va emotsional qoniqish manbaiga aylanishi tarbiya haqida keng malumot bermoqda.